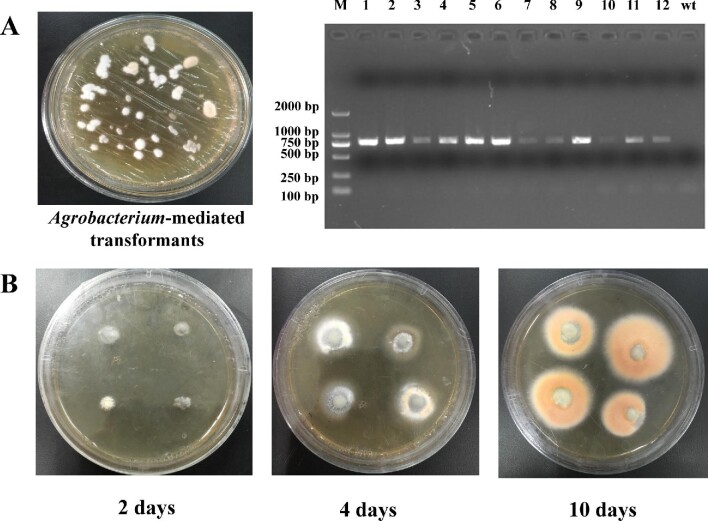
圖 5.

液態發酵過程中牛樟芝生物合成安托醌醇需求的遺傳證據
摘要
牛樟芝固態發酵可產生多種泛醌化合物,如安托醌醇(AQ)。然而,AQ 在液態發酵 (LSF) 過程中幾乎不會合成。為了研究 AQ 合成的機制,在 LSF 中添加了三種前驅物(泛醌 0 UQ0、法呢醇和法呢基二磷酸 FPP)。結果表明,UQ0成功誘導AQ產生;然而,金合歡醇和FPP不能誘導AQ合成。限制AQ合成的前驅物是醌環,而不是異戊二烯側鏈。然後,建立了農桿菌介導的香樟轉化系統,並過度表現醌環修飾(coq2-6)和異戊二烯合成(HMGR,fps)基因。結果表明,過度表現異戊二烯側鏈合成基因並不能增加AQ的產量,但過度表現coq2和coq5可以顯著增加AQ的產量。這與前驅體的實驗結果一致。這顯示樟芝在LSF製程中缺乏修飾AQ醌環的能力。在修飾步驟中,UQ0 的異戊二烯化是 AQ 生物合成的關鍵步驟。此結果將有助於我們了解樟芝AQ生物合成所需的遺傳證據。 jpg" alt="圖1。 />
圖1.
不同濃度的影響...
圖1.
不同濃度的潮黴素的影響B對樟芝生長的影響…
圖1.不同濃度潮黴素B對樟芝S-29生長的影響。 A:樟芝S-29的細胞年齡為8天; B:香樟S-29的細胞年齡為31天。以20、40、60和80 mg/L潮黴素B的細胞生長情形及不含抗生素的平板作為對照。
圖2.
農桿菌介導的轉殖系統...
圖2.
農桿菌介導的轉化香樟 S-29 系統。 A:農桿菌的選擇…
圖2. 農桿菌介導的樟芝S-29 轉化系統。 A:選擇根癌農桿菌; B:樟芝S-29細胞年齡; C:香樟S-29生物質; D:根癌農桿菌LBA4404和樟芝S-29的共培養時間; E:共培養溫度; F:根癌農桿菌LBA4404濃度; G:乙醯丁香酮濃度; H:振盪持續時間; I:香樟S-29轉化子hyg基因的PCR檢測(wt:野生型;M:DL2000的Maker;1-6:香樟S-29轉化子)。結果表示為每個實驗組的平均值±SEM (n = 3)。使用Dunnett檢定的單因子變異數分析來評估資料之間差異的顯著性,顯著水準設定為p<1。 0.05。
圖3.
評估外源添加的作用...
圖3.
評估外源添加的作用AQ 生物合成的前驅物。 A:色譜圖...
圖 3. 評估外源性加成前驅物對 AQ 生物合成的作用。 A:SSF 中香樟的色譜圖; B:LSF 中樟芝的色譜圖; C:AQ是UQ3的結構類似物; D:加入了 UQ0 的 LSF 中樟芝的色譜圖; E:添加法尼醇的 LSF 中樟芝的色譜圖; F:加入 FPP 的 LSF 中樟芝的色譜圖; G:加入 UQ0 和金合歡醇的 LSF 中樟芝的色譜圖; H:加入了 UQ0 和 FPP 的 LSF 中樟芝的色譜圖; I:不同組別的 AQ 和 Ac 產量。
圖 4.
重組質粒的建構...
圖 4.
重組質粒的建構on pCAMBIA 1301 . A: A. Camphorata S-29…
圖4. 基於pCAMBIA 1301. A: A. Camphorata S-29 和目的基因(coq2、coq3、coq5、 coq6、fps、HMGR); B:基於 pCAMBIA 1301 建立質粒並在根癌農桿菌 LBA4404 中進行驗證。 M、M1 和 M2 = 不同分子量的 DNA 標記。目標基因:q2 = coq2、q3 = coq3、q5 = coq5、q6 = coq6、HMGR = HMG-CoA 還原酶、fps = FPP 合成酶。 wt = 野生型。
圖 5.
香樟 S-29 的轉化…
圖 5.
轉化香樟S-29 。 A:農桿菌介導的轉化體和 hyg 的檢測...
圖 5. 香樟 S-29 的轉化。 A:農桿菌介導的轉化體以及香樟S-29轉化體中hyg基因的檢測。 B:樟腦 S-29 轉化體在含有潮黴素 B 的 PDA 平板中生長。 wt = 野生型。
圖 6.
醌過度表現的影響...
圖 6.
醌環過度表現的影響樟芝S-29 的修飾基因對...
圖6. 樟芝S-29 的醌環修飾基因過度表現對AQ 生物合成的影響。 A:不同轉化體中AQ和Ac的產量。 B:pCAMBIA1301轉化體的菌落形態和色譜圖。 C:pCAMBIA1301-coq2轉化子的菌落形態和色譜圖。 D:pCAMBIA1301-coq3轉化子的菌落形態和色譜圖。 E:pCAMBIA1301-coq5轉化體的菌落形態和色譜圖。 F:pCAMBIA1301-coq6轉化子的菌落形態和色譜圖。
圖7.
側鏈過度表現的影響...
圖7.
側鏈過度表現的影響樟芝 S-29 基因對 AQ…
圖 7. 樟芝 S-29 側鏈基因過度表現對 AQ 生物合成的影響。 A:不同轉化體中AQ和Ac的產量。 B:pCAMBIA1301轉化體的菌落形態和色譜圖。 C:pCAMBIA1301-fps 轉化子的菌落形態和色譜圖。 D:pCAMBIA1301-HMGR 轉化子的菌落形態和色譜圖。
圖 8.
AQ 合成的全域途徑...
圖 8.
AQ 合成的全域途徑在香樟中。作為前驅物,...
圖 8. 樟腦中 AQ 合成的整體途徑。 UQ0作為前驅物可以顯著減少AQ的合成步驟。 所有人物 (8)